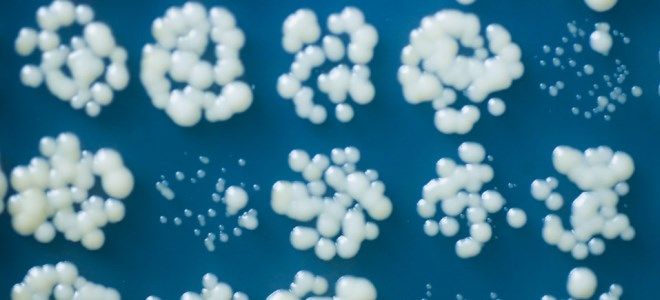
грибок кандида на ногах грибок кандида на ногах

Кандидозы у женщин, вызванные грибком Кандида, — распространённая проблема, проявляющаяся в различных формах и локализациях. Симптомы варьируются от зуда и жжения до выделений, что делает тему актуальной. В статье рассмотрим основные виды кандидозов, их симптомы, методы лечения и причины возникновения. Это поможет женщинам лучше понять своё состояние и своевременно обратиться за медицинской помощью. Знание о кандидозах и их лечении позволит избежать осложнений и улучшить качество жизни.
Виды кандидоза у женщин
В большинстве случаев инфекционный процесс вызывается грибком Кандида аурис. Этот патоген может поражать слизистые оболочки половых органов, кишечник и кожу. Согласно данным Всемирной организации здравоохранения, примерно 20% населения Земли хотя бы раз сталкивались с кандидозом. Однако сами по себе грибы Кандида являются одними из самых распространенных и безвредных обитателей человеческого организма.
Долгое время колония этих микроорганизмов может оставаться неактивной, но при ослаблении иммунной системы наблюдается их активный рост. В результате этого развиваются кандидозы у женщин, симптомы и методы лечения которых взаимосвязаны.
В зависимости от пораженных органов, различают:
- кандидоз ротовой полости;
- кандидоз кишечника;
- кандидоз кожи;
- генитальный кандидоз.
Кандидозы у женщин представляют собой распространенную проблему, вызываемую грибком рода Кандида. Эксперты отмечают, что основными симптомами являются зуд, жжение, выделения с характерным запахом и дискомфорт при мочеиспускании. Эти проявления могут значительно ухудшить качество жизни, поэтому важно своевременно обратиться к врачу. Лечение кандидозов обычно включает противогрибковые препараты, как местного, так и системного действия. Врачи подчеркивают, что для успешной терапии необходимо учитывать индивидуальные особенности пациентки, а также возможные предрасполагающие факторы, такие как гормональные изменения, стресс и неправильное питание. Профилактика также играет ключевую роль: соблюдение гигиенических норм и поддержание иммунной системы могут существенно снизить риск рецидивов.
https://youtube.com/watch?v=0ukpn-CUevE
Кандидозы у женщин – причины возникновения
Трудно однозначно определить, что именно вызывает кандидоз у женщин и при каких условиях он развивается – факторы, способствующие этому заболеванию, весьма разнообразны. Чаще всего причиной становится ослабление иммунной системы, что приводит к активному размножению грибка.
К числу распространенных провоцирующих факторов можно отнести:
- частые стрессы и эмоциональные переживания;
- длительное использование гормональных контрацептивов;
- терапию глюкокортикоидами или антибиотиками;
- травмы органов репродуктивной системы, а также проведение гинекологических операций (например, конизация шейки матки, удаление кист);
- аборты;
- период беременности и родов;
- радиотерапию при лечении онкологических заболеваний;
- прием цитостатических средств.
| Вид кандидоза | Симптомы | Лечение |
|---|---|---|
| Вульвовагинальный кандидоз (молочница) | Зуд, жжение, покраснение, отек половых губ и влагалища; творожистые выделения белого цвета; боль при мочеиспускании и половом акте. | Противогрибковые препараты местного действия (кремы, свечи, вагинальные таблетки) – клотримазол, миконазол, нистатин. В тяжелых случаях – системные противогрибковые препараты (флуконазол). |
| Кандидоз кожи и ногтей | Покраснение, зуд, шелушение, мокнутие в складках кожи (под грудью, в паху, между пальцами); белые или желтоватые пятна на ногтях, утолщение и крошение ногтевой пластины. | Противогрибковые мази, кремы, растворы (клотримазол, кетоконазол, тербинафин). При поражении ногтей – лаки с противогрибковым действием, в некоторых случаях – системные препараты. |
| Орофарингеальный кандидоз (молочница полости рта) | Белый налет на языке, слизистой щек, деснах, миндалинах; болезненность при глотании; жжение во рту; трещины в уголках рта. | Противогрибковые растворы для полоскания (нистатин, клотримазол), таблетки для рассасывания, в тяжелых случаях – системные препараты. |
| Кандидоз кишечника | Вздутие живота, метеоризм, диарея или запоры, боли в животе, слизь в стуле, общая слабость, утомляемость. | Противогрибковые препараты для приема внутрь (нистатин, флуконазол), пробиотики для восстановления микрофлоры кишечника, диета с ограничением сахара и дрожжей. |
| Инвазивный кандидоз (системный) | Лихорадка, озноб, общая слабость, поражение внутренних органов (почек, печени, сердца, легких, мозга) с соответствующими симптомами. | Системные противогрибковые препараты (флуконазол, каспофунгин, амфотерицин В) под строгим контролем врача, часто в условиях стационара. |
Интересные факты
Вот несколько интересных фактов о кандидозах у женщин:
-
Разнообразие видов грибка: Хотя наиболее известным возбудителем кандидоза является Candida albicans, существует более 200 видов грибов рода Candida. Некоторые из них, такие как Candida glabrata и Candida tropicalis, могут вызывать инфекции, особенно у женщин с ослабленным иммунитетом или при длительном использовании антибиотиков.
-
Влияние гормонов: Гормональные изменения, такие как те, что происходят во время менструации, беременности или при использовании гормональных контрацептивов, могут способствовать развитию кандидоза. Эстроген может увеличивать уровень гликогена в вагинальной среде, что создает благоприятные условия для роста грибка.
-
Психосоматические факторы: Стресс и эмоциональное состояние могут влиять на иммунную систему, что, в свою очередь, может способствовать развитию кандидозов. Исследования показывают, что женщины, испытывающие высокий уровень стресса, могут быть более подвержены грибковым инфекциям, включая кандидоз.
Эти факты подчеркивают важность комплексного подхода к диагностике и лечению кандидозов, включая внимание к гормональному фону и психоэмоциональному состоянию пациенток.
https://youtube.com/watch?v=6YscvCl77uI
Кандидозы у женщин – симптомы
Чаще всего кандидоз у женщин проявляется ярко выраженными симптомами. Первые признаки заболевания могут подсказать о его начале. Увеличение активности грибка приводит к усилению обменных процессов и выделению веществ, которые раздражают слизистую оболочку. Зуд, жжение и дискомфорт в области поражения – это первые знаки кандидоза. В общем, клинические проявления кандидозов у женщин, а также их симптомы и методы лечения зависят от того, какой орган затронут и где именно происходит патологический процесс.
Вагинальный кандидоз у женщин
Этот вид заболевания является наиболее распространенным. Это связано с тем, что грибок Кандида является частью нормальной микрофлоры и всегда присутствует в небольших количествах во влагалище. В мазке у женщин грибок Кандида обычно обнаруживается в минимальных концентрациях. Однако при возникновении благоприятных условий для его роста начинается активное размножение.
К этому способствуют:
- снижение местного иммунитета;
- переохлаждение организма;
- ослабление иммунной системы;
- гормональные нарушения.
При развитии кандидоза влагалища наблюдаются характерные симптомы:
- зуд и раздражение наружных половых органов;
- образование язвочек на гениталиях;
- появление белых выделений, напоминающих творог;
- болезненные ощущения при мочеиспускании или половом акте.
Грибок Кандида во рту
Поражение слизистых оболочек ротовой полости чаще всего наблюдается у младенцев. Это происходит из-за того, что новорожденный может заразиться грибком, проходя через инфицированные родовые пути матери. Признаки инфекции могут проявиться спустя несколько недель после рождения. У взрослых грибок Кандида в горле встречается реже.
Основные места, где грибок может обитать:
- пораженные участки слизистой оболочки;
- кариозные зубы;
- крипты миндалин.
Кандидозы у женщин, симптомы и лечение которых напоминают классическую форму, могут возникать в результате орального секса.
В зависимости от клинической картины выделяют три типа кандидозного поражения ротовой полости:
- кандидозный хейлит – поражение внешней каймы губ;
- глоссит – поражение языка;
- стоматит – поражение слизистых оболочек рта.
В каждом из этих случаев основным симптомом является плотный белесый налет, напоминающий творог. Под этим налетом часто скрывается эрозированная красная поверхность. Также могут появляться трещины и язвы, что приводит к ощущению жжения в ротовой полости. Прием пищи становится болезненным и вызывает значительный дискомфорт.
Грибок Кандида в кишечнике
В кишечнике обитает множество микроорганизмов и грибков. При снижении иммунной защиты или наличии заболеваний внутренних органов они начинают активно размножаться, что приводит к дисбалансу микрофлоры желудочно-кишечного тракта и развитию кандидоза. В результате возникают характерные симптомы.
Симптомы кандидоза у женщин при поражении кишечника могут включать:
- дискомфорт и болезненные ощущения в области живота;
- диарею, иногда с выделениями белого цвета;
- повышенное газообразование;
- ощущение неполного опорожнения кишечника;
- снижение аппетита;
- общую слабость;
- апатию.
В зависимости от особенностей поражения выделяют следующие формы заболевания:
- Инвазивная – встречается редко и протекает в тяжелой форме.
- Неинвазивная – возникает из-за активного размножения грибка, связанного с гиперчувствительностью организма.
- Фокальная – развивается вследствие повреждения слизистых оболочек кишечника, часто при заболеваниях двенадцатиперстной кишки или язвенном колите.
Грибок Кандида на коже
Симптоматика кандидоза кожи проявляется в виде воспалительных участков на поверхности кожи. Можно заметить образование мелких пузырьков, заполненных прозрачной жидкостью. Пораженные области имеют четкие границы и ярко-красный цвет. После разрыва пузырьков на их месте возникают эрозии. Кожа начинает трескаться и зудеть. Инфекция распространяется довольно быстро. Чаще всего из-за недостаточной силы иммунной системы этому заболеванию подвержены дети младше одного года.
Схожие формы кандидоза у женщин, симптомы и методы лечения которых аналогичны, возникают при системном заражении организма. В этом случае выделяют следующие виды кожного кандидоза:
- поражение крупных кожных складок;
- межпальцевые эрозии – грибок Кандида локализуется именно в этой области на ногах;
- паронихии (поражение ногтевых пластин);
- кандидоз волосистой части головы.
Как определить грибок Кандида в организме?
Предположить наличие патогена можно, основываясь на описанных ранее симптомах, однако на ранних этапах они могут отсутствовать. В таких ситуациях выявить грибок Кандида бывает затруднительно, и анализы становятся ключевым методом диагностики. Для обнаружения грибка проводят прямой посев и культивацию.
В качестве объектов исследования могут использоваться различные биологические жидкости:
- выделения из влагалища;
- кровь;
- мокрота.
Посевы требуют определенного времени для получения результатов, поэтому в случае необходимости срочной диагностики применяются альтернативные методы:
- серологические – определение антигенов и антител к Candida spp;
- гистологическое исследование – применяется для диагностики диссеминированного кандидоза;
- ПЦР-диагностика – используется при поражении глаз.
Кандидозы у женщин – лечение
Многие женщины, сталкивающиеся с этой проблемой, часто задумываются о том, как избавиться от грибка Кандида в своем организме. Важно отметить, что в этом нет особой необходимости. Грибок Кандида альбиканс является частью нормальной микрофлоры влагалища, поэтому его полное уничтожение практически невозможно. Более того, такие меры могут негативно сказаться на здоровье репродуктивной системы.
С учетом этих нюансов, лечение должно быть индивидуально адаптировано, принимая во внимание общее состояние здоровья. В целом, терапия включает в себя следующие этапы:
- Устранение провоцирующих факторов.
- Снижение уровня грибка.
- Восстановление нормальной микрофлоры.
Схема лечения кандидоза у женщин
Перед тем как приступить к лечению молочницы у женщин, специалисты проводят ряд диагностических процедур. Эти мероприятия направлены на выявление факторов, способствующих развитию заболевания. Грибок присутствует в организме постоянно, но его активное размножение запускается под воздействием определенных причин.
Врачи разрабатывают индивидуальный план терапии, который включает в себя:
- Устранение предрасполагающих факторов (укрепление иммунной системы, грамотное применение антибиотиков, соблюдение правил личной гигиены).
- Местное медикаментозное лечение молочницы (в большинстве случаев достаточно одного препарата).
- Соблюдение диеты.
- Отказ от вредных привычек.
Кандидозы у женщин – лечение, препараты
Препараты для лечения молочницы у женщин широко представлены на фармацевтическом рынке. Эти лекарства доступны как в виде средств для местного использования (мазей, кремов), так и в форме таблеток. В большинстве случаев врачи предпочитают первую категорию, тогда как таблетки чаще назначаются при хронических формах кандидоза. Мази и свечи действуют непосредственно на источник инфекции, обеспечивая быстрое подавление роста и активности грибка. Результат можно заметить уже после первого применения.
Среди популярных препаратов для лечения молочницы можно выделить:
- Бутоконазол (крем 2%);
- Кетоконазол – известные свечи от кандидоза для женщин;
- Флуконазол (таблетки);
- Клотримазол (вагинальные таблетки);
- Сертаконазол (суппозитории);
- Нистатин (влагалищные таблетки).
Кандидозы у женщин – лечение народными средствами
Обсуждая методы лечения молочницы у женщин, специалисты подчеркивают, что использование народных средств может быть допустимым. Тем не менее, важно помнить, что неправильное применение трав может усугубить проблему. Вот несколько эффективных рецептов из народной медицины.
Содовые ванночки
Ингредиенты:
- пищевая сода – 1 чайная ложка;
- вода – 1 литр.
Приготовление и использование
- Растворите соду в теплой кипяченой воде.
- Перелейте полученный раствор в чистую емкость.
- Принимайте сидячие ванночки в течение 30 минут.
Отвар из календулы
Ингредиенты:
- цветки календулы – 1 чайная ложка;
- вода – 250 мл.
Приготовление и использование
- Залейте цветки кипятком и поставьте на водяную баню.
- Варите в течение 20 минут.
- Остудите, процедите и используйте для спринцевания или принимайте по половине стакана натощак в день.
Диета при кандидозе у женщин
Диета при кандидозе играет ключевую роль в успешном лечении. Важно исключить из рациона все те продукты, которые способствуют развитию патогенной микрофлоры. Независимо от того, где находится грибок – будь то во влагалище или в горле – соблюдение диеты должно быть обязательным элементом терапии.
Следующие продукты следует исключить:
- сладкие кондитерские изделия;
- сахар;
- картофель;
- цельное молоко;
- рис;
- шоколад;
- макароны;
- жирные виды мяса (например, свинина и баранина);
- алкогольные напитки.
В то же время рекомендуется увеличить потребление продуктов, которые подавляют рост и размножение грибка:
- брусника;
- морковь;
- морская капуста;
- острый перец;
- гвоздика;
- лимон;
- лавровый лист.
https://youtube.com/watch?v=HjcRGyWHH64
Профилактика кандидозов у женщин
Профилактика кандидозов у женщин является важным аспектом поддержания здоровья и предотвращения рецидивов заболевания. Грибок Кандида, который вызывает кандидоз, является частью нормальной микрофлоры организма, однако при определенных условиях он может начать активно размножаться, что приводит к инфекционным процессам. Рассмотрим основные меры профилактики, которые помогут снизить риск развития кандидозов.
1. Поддержание нормальной микрофлоры
Одним из ключевых факторов в профилактике кандидозов является поддержание баланса микрофлоры. Для этого рекомендуется:
- Избегать чрезмерного употребления антибиотиков, так как они могут нарушить баланс микрофлоры, уничтожая как патогенные, так и полезные бактерии.
- Включать в рацион продукты, способствующие росту полезных бактерий, такие как йогурты, кефир и другие ферментированные продукты.
- При необходимости использовать пробиотики, которые помогут восстановить нормальную флору после приема антибиотиков.
2. Соблюдение гигиенических норм
Личная гигиена играет важную роль в профилактике кандидозов. Рекомендуется:
- Регулярно менять нижнее белье, предпочтительно из натуральных тканей, которые позволяют коже дышать.
- Избегать использования синтетических прокладок и тампонов на длительный срок, так как они могут создавать благоприятную среду для размножения грибка.
- Соблюдать правила интимной гигиены, включая регулярное мытье половых органов с использованием мягких, неагрессивных средств.
3. Правильное питание
Рациональное питание также может снизить риск развития кандидозов. Рекомендуется:
- Сократить потребление сахара и углеводов, так как они способствуют росту грибка Кандида.
- Увеличить потребление овощей, фруктов и белков, которые поддерживают иммунную систему и общее здоровье организма.
- Пить достаточное количество воды для поддержания гидратации и нормального функционирования организма.
4. Укрепление иммунной системы
Сильная иммунная система помогает организму бороться с инфекциями, включая кандидозы. Для этого рекомендуется:
- Регулярно заниматься физической активностью, что способствует улучшению обмена веществ и укреплению иммунитета.
- Соблюдать режим сна и отдыха, так как недостаток сна может ослабить иммунные функции.
- Избегать стрессов и находить способы для их управления, такие как медитация, йога или хобби.
5. Регулярные медицинские осмотры
Профилактика кандидозов также включает в себя регулярные визиты к врачу. Это поможет:
- Своевременно выявлять и лечить любые инфекции или нарушения, которые могут способствовать развитию кандидозов.
- Получать рекомендации по индивидуальной профилактике, исходя из состояния здоровья и особенностей организма.
Следуя этим рекомендациям, женщины могут значительно снизить риск развития кандидозов и поддерживать свое здоровье на высоком уровне. Важно помнить, что при появлении первых симптомов заболевания необходимо обратиться к врачу для получения квалифицированной помощи и назначения адекватного лечения.
Вопрос-ответ
Каковы основные симптомы кандидоза у женщин?
Основные симптомы кандидоза у женщин включают зуд и жжение в области влагалища, белые творожистые выделения, дискомфорт при половом акте и болезненное мочеиспускание. Также могут наблюдаться покраснение и отек наружных половых органов.
Какие факторы могут способствовать развитию кандидоза?
Факторы, способствующие развитию кандидоза, включают ослабление иммунной системы, длительное использование антибиотиков, гормональные изменения (например, во время беременности или менопаузы), а также неправильное питание и стресс.
Как лечится кандидоз у женщин?
Лечение кандидоза обычно включает противогрибковые препараты, которые могут быть назначены в виде таблеток, кремов или свечей. Важно также соблюдать гигиену, избегать раздражающих веществ и поддерживать здоровый образ жизни для предотвращения рецидивов.
Советы
СОВЕТ №1
Регулярно проходите медицинские осмотры и консультации у гинеколога. Это поможет выявить кандидоз на ранних стадиях и предотвратить его развитие.
СОВЕТ №2
Обратите внимание на свой рацион питания. Уменьшите потребление сахара и углеводов, так как они способствуют размножению грибка Кандида. Включите в меню больше пробиотиков, таких как йогурт и кефир, чтобы поддерживать здоровую микрофлору.
СОВЕТ №3
Избегайте использования синтетического нижнего белья и тесной одежды. Предпочитайте натуральные ткани, такие как хлопок, которые позволяют коже дышать и уменьшают риск развития грибковых инфекций.
СОВЕТ №4
Не занимайтесь самолечением. При появлении симптомов кандидоза, таких как зуд, жжение или выделения, обратитесь к врачу для получения правильного диагноза и назначения адекватного лечения.